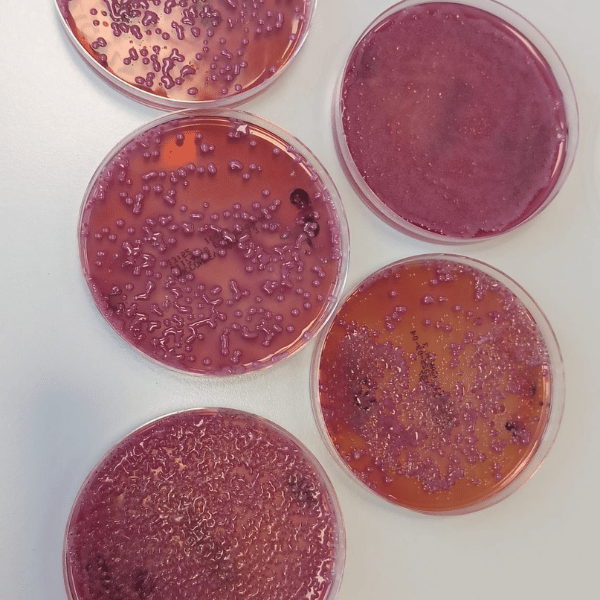

Dairy Vet Services s.r.l S.T.P nasce dalla passione condivisa di tre colleghi (Dott. Filippini, Dott. Gorrieri, Dott. Valentini Cristiano) per la medicina veterinaria, una passione coltivata negli anni attraverso l’esperienza sul campo, il confronto continuo e la volontà di offrire un servizio sempre più qualificato agli allevatori e ai professionisti del settore.
Su questo principio, fondato su competenza, collaborazione e fiducia reciproca, è maturata l’idea di creare un gruppo strutturato, composto da collaboratori selezionati e altamente preparati, ai quali fornire strumenti concreti e risorse avanzate per ottimizzare il proprio lavoro quotidiano. L’obiettivo non è solo quello di intervenire, ma di prevenire, migliorare e innovare costantemente l’approccio alla salute animale, con un’attenzione particolare alla gestione moderna dell’allevamento.
Da questa visione è nata l’esigenza di potenziare l’aspetto diagnostico, considerato un pilastro fondamentale per garantire interventi tempestivi, mirati ed efficaci. Come naturale evoluzione di questo percorso, tutte le energie e gli investimenti sono stati convogliati nella realizzazione di un laboratorio di analisi interno, progettato per offrire risultati rapidi, affidabili e scientificamente solidi.
Oggi il laboratorio rappresenta uno strumento strategico imprescindibile: un vero punto di forza che consente di supportare in modo concreto le decisioni cliniche, migliorare le performance aziendali e tutelare il benessere animale. Grazie a questa struttura, Dairy Vet Services continua a crescere, consolidando la propria identità come realtà dinamica, orientata alla qualità, all’innovazione e alla collaborazione professionale.